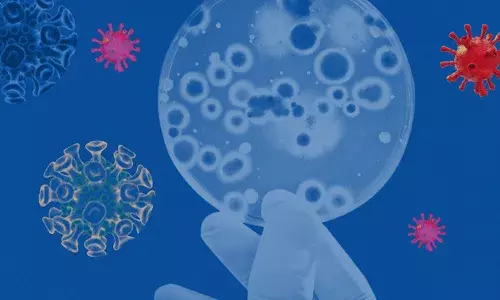
Omicron India (tv5news.in)

- Home
- /
- #Covid Cases

#Covid Cases
Get Latest News, Breaking News about #Covid Cases. Stay connected to all updated on #Covid Cases
దేశంలో పెరుగుతున్న కోవిడ్ కేసులు.. ఢిల్లీలో 562, అగ్రస్థానంలో కేరళ..
- By 6 Jun 2025 2:38 PM IST
Covid-19: భారత్పై మరోసారి కరోనా మహమ్మారి పంజా.. దేశంలో మూడువేల యాక్టివ్ కోవిడ్కే సులు
- By 31 May 2025 10:30 AM IST
Covid-19: కరోనాతో వణికిపోతున్న అమెరికా..కొత్త వేరియంట్ వ్యాప్తి!
- By 28 May 2025 12:15 PM IST
పెరుగుతున్న కోవిడ్ కేసులు.. బెడ్ లు, ఆక్సిజన్ సిద్ధంగా ఉంచాలని ఆసుపత్రులకు ఆదేశాలు
- By 24 May 2025 2:36 PM IST
Corona 4th Wave: దేశంలో పెరుగుతున్న కరోనా కేసులు.. ఫోర్త్ వేవ్కు సంకేతమా..?
- By 9 Jun 2022 5:00 PM IST
North Korea: ఒక్కరోజే 2 లక్షల 70 వేల కోవిడ్ కేసులు.. కిమ్ రాజ్యంలో కీలక పరిణామాలు..
- By 18 May 2022 3:15 PM IST
China: 27 వేలకుపైగా కరోనా కేసులు.. అందులో 914 మందికి మాత్రమే లక్షణాలు..
- By 12 April 2022 8:45 AM IST
India Corona: కరోనా డేంజర్ బెల్స్.. గతంలో ఎన్నడూ లేనంతగా రికార్డ్ స్థాయిలో కేసులు..
- By 18 Jan 2022 8:57 AM IST
Covid Cases: ఏపీలో 24 గంటల్లో 4,570 పాజిటివ్ కేసులు.. తెలుగు రాష్ట్రాల్లో కరోనా డేంజర్ బెల్స్..
- By 17 Jan 2022 10:00 AM IST
Corona Update: 15 లక్షలు దాటిన కరోనా యాక్టివ్ కేసుల సంఖ్య.. తెలుగు రాష్ట్రాల్లో..
- By 16 Jan 2022 5:31 PM IST
Election Commission: కరోనా కేసులు పెరుగుతున్న వేళ ఈసీ కీలక నిర్ణయం.. వాటన్నింటికీ నో పర్మిషన్..
- By 15 Jan 2022 7:00 PM IST
Corona Update: దేశంలో కొత్తగా 2 లక్షల కరోనా కేసులు.. 3.85 శాతానికి పెరిగిన ఇన్ఫెక్షన్ రేటు..
- By 15 Jan 2022 5:34 PM IST
Covid Cases: వేల నుండి లక్షలకు చేరిన కరోనా కేసులు.. నైట్ కర్ఫ్యూ వైపే అన్ని రాష్ట్రాల చూపు..
- By 12 Jan 2022 10:23 AM IST
Covid Cases: పార్లమెంట్ సిబ్బందికి కరోనా పరీక్షలు.. 350 మందికి పాజిటివ్..
- By 9 Jan 2022 3:20 PM IST
Covid Cases: వచ్చేవారం నుండి రోజుకు 4-8 లక్షల కొత్త కేసులు నమోదయ్యే అవకాశం..!
- By 7 Jan 2022 6:45 PM IST
Maharashtra Cabinet: పదిమందికి పైగా మంత్రులు.. 20కు పైగా ఎమ్మెల్యేలకు కరోనా..
- By 1 Jan 2022 7:36 PM IST
Omicron India: రోజురోజుకీ పెరుగుతున్న ఒమిక్రాన్ కేసులు.. న్యూ ఇయర్ వేడుకలపై ఆంక్షలు..
- By 27 Dec 2021 8:30 PM IST
Omicron India: పెరుగుతున్న ఒమిక్రాన్ కేసుల సంఖ్య.. ప్రస్తుతం దేశంలో..
- By 20 Dec 2021 8:35 AM IST
Omicron India: భారత్లోని 11 రాష్ట్రాల్లో ఒమిక్రాన్ వేరియంట్ కేసుల సంఖ్య ఎంతంటే..
- By 17 Dec 2021 8:15 PM IST
Omicron India: తెలుగు రాష్ట్రంలో తొలి ఒమిక్రాన్ వేరియంట్ కేసు..
- By 12 Dec 2021 12:22 PM IST
Omicron India: ఇండియాలో విజృంభిస్తున్న ఒమిక్రాన్ వేరియంట్.. నైట్ కర్ఫ్యూ ఆలోచనలో కేంద్రం..
- By 11 Dec 2021 9:45 PM IST
Omicron India: దేశంలో అయిదుకు పెరిగిన ఒమిక్రాన్ బాధితుల సంఖ్య.. ఢిల్లీలో..
- By 5 Dec 2021 3:31 PM IST
corona update: మళ్లీ పెరుగుతున్న కరోనా కేసులు.. నిన్నటి కంటే ఎక్కువగా..
- By 15 Sept 2021 11:10 AM IST
© Copyright 2025 : tv5news.in. All Rights Reserved. Powered by hocalwire.com